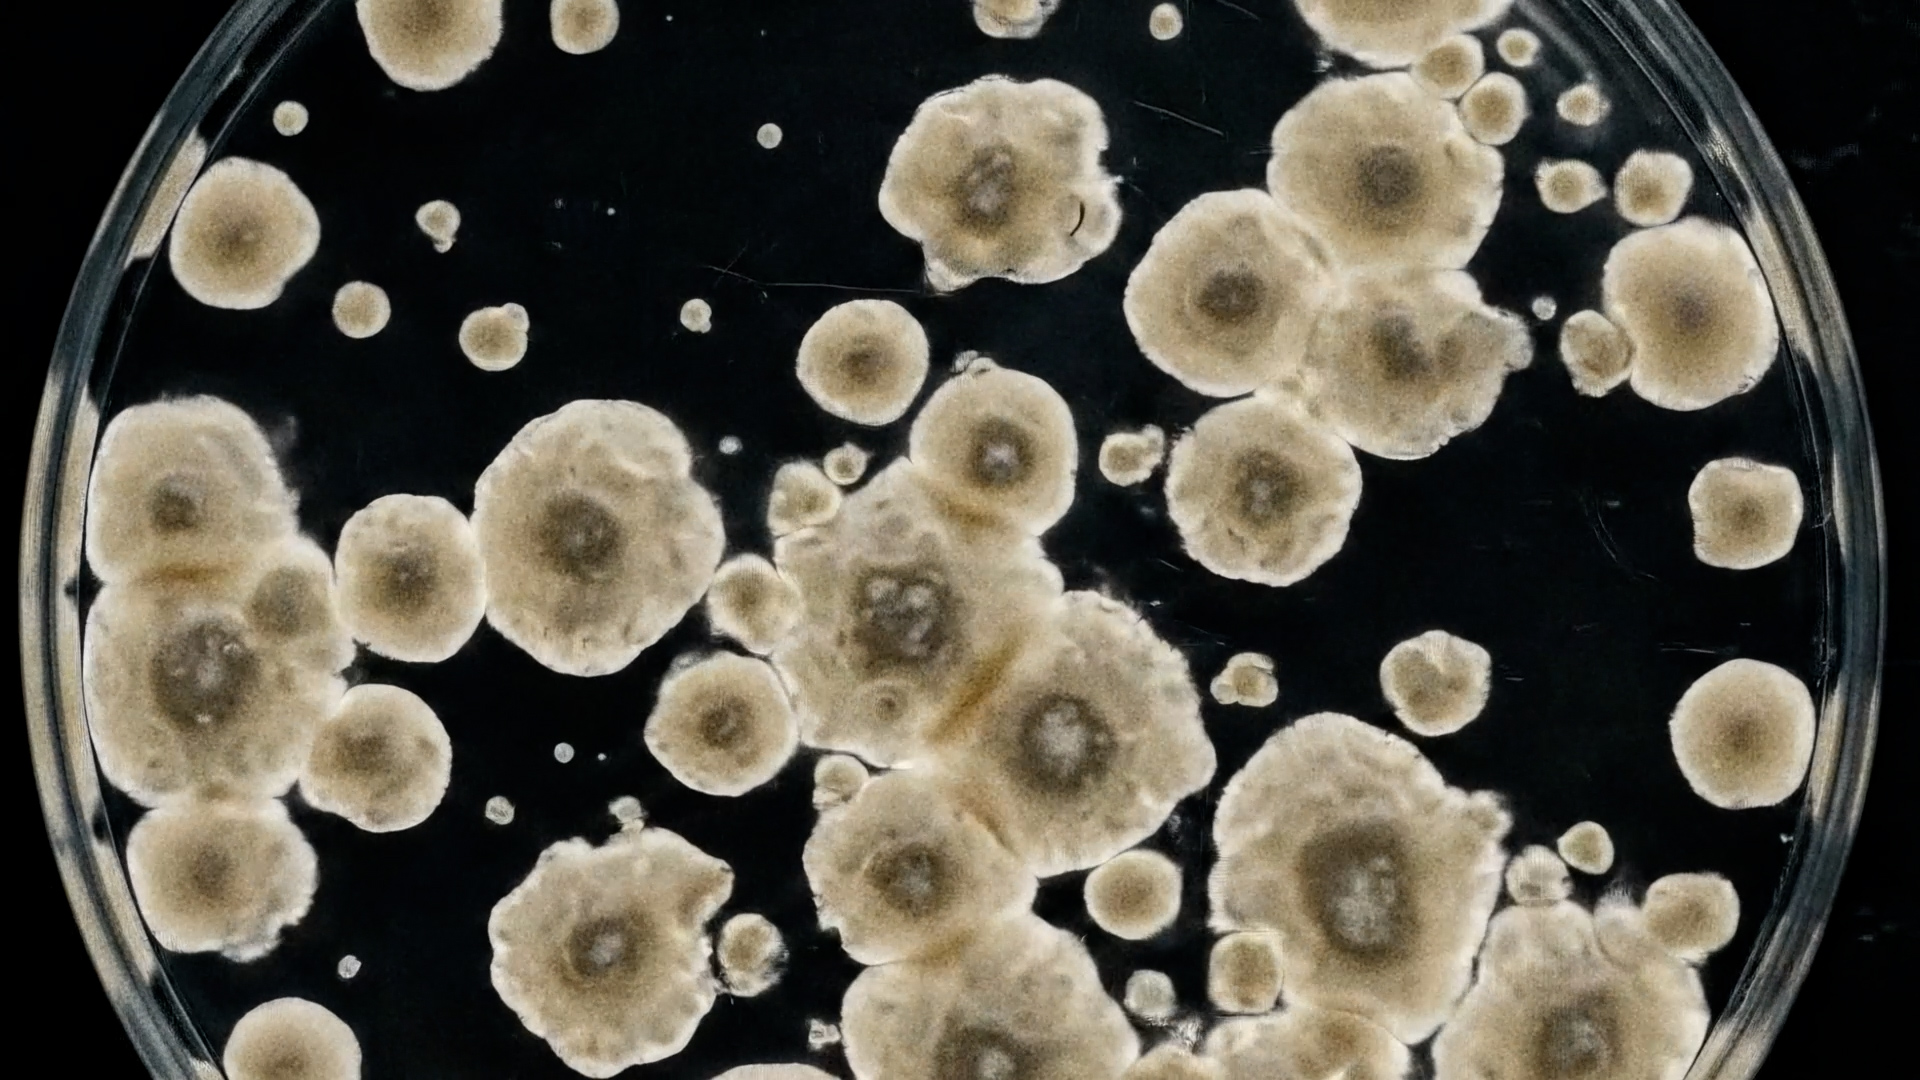

Science Is Our Best Defense
The Ragon Institute
Branded Short, Brand Documentary, Short Film
A cinematic exploration of how the Ragon Institute unites brilliant minds to accelerate vaccine and immune research and why supporting this work is critical to shaping the future of global health.
Key Credits
- Director
- Paula Chowles
- Head of Production
- Zuberoa Marcos
- Cinematographer
- Dan Kennedy
- Producer
- Genevieve Skehan
- Senior Post Producer
- Caity Keyes
- Editor
- Jim Allison
- Motion Designer
- Melody Fitzgerald
- Composers
- Timo Elliston
- Brian Jones
This short film brings viewers inside the mission of the Ragon Institute, where collaborators across disciplines push the boundaries of vaccine and immune research.
As government funding for scientific research tightens, the institute faced a critical challenge: how to inspire philanthropists to step forward and help sustain breakthroughs that cannot afford to slow down.
Through intimate, human-centered storytelling and visually rich scenes, the film reveals both the urgency and the possibility behind cutting-edge science, reframing philanthropic support not as charity, but as essential partnership in discovery. It highlights not just what the institute studies, but why that research matters, positioning immune science as one of our strongest defenses in protecting global health and advancing humanity.